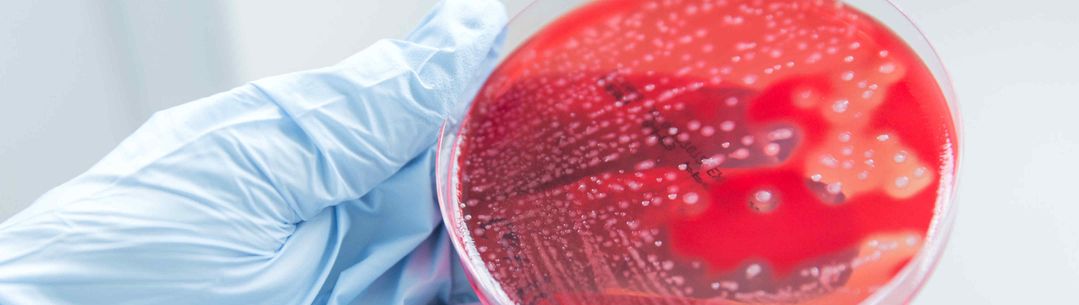

Adult Infectious Disease
The Section of Adult Infectious Disease undertakes world-leading innovative research with a strong translational component. The Section has six research themes, namely: AMR and healthcare-associated infection, tuberculosis, gram- positive infections, respiratory infections, inflammation and sepsis, and international health. As well as hosting the NIHR Health Protection Unit (HPRU) in AMR and HCAI, with strong collaborations with Public Health England, academics in the Section participate in other HPRU’s across the Faculty, the MRC Centre for Molecular Bacteriology & Infection (CMBI) and the KEMRI Wellcome Trust Research Programme. Section members lead a number of cross-faculty themes including the Imperial Network for Vaccine Research (INVaR) and the Antimicrobial Resistance Collaborative (ARC).
The Section is based in modern facilities that house state of the art category 2 and category 3 pathogen containment laboratories. Senior staff members have diverse collaborative links across the world, and several are primarily based overseas in Peru, South Africa, Uganda and Kenya.
The Section of Adult Infectious Disease has a strong profile in the area of clinical and non-clinical education in infection, teaching both undergraduates, for example, Year 5 and Year 6 MBBS students and postgraduates. It is the home of the popular MSc in Molecular Medicine. Many PhD students including a large number of Wellcome Trust and MRC Clinical Research Training Fellows are based in the Section. We also welcome a range of BSc, MSc and other project students. The Section operates in close liaison with the clinical infection service at Imperial College Healthcare NHS Trust, with many dual appointments across Imperial College and the Trust
Research groups and centre leadership
Research themes
A selection of the Section's key research areas, units and networks:
- AMR and healthcare-associated infection
- Tuberculosis
- Gram- positive infections
- Respiratory infections
- Inflammation and sepsis
- International health
- NIHR Health Protection Research Unit in Antimicrobial Resistance and Healthcare Associated Infection
- NIHR Health Protection Research Unit in Respiratory Infections
- Imperial Network for Vaccine Research (INVaR)
- Antimicrobial Resistance Collaborative (ARC).
Section leadership
Professor Shiranee Sriskandan
Section Head, Adult Infectious Disease
Shiranee Sriskandan is Professor of Infectious Diseases and the theme lead for the NIHR Health Protection Research Unit (HPRU) in Healthcare Associated Infection and Antimicrobial Resistance. Her research focusses on the potential mechanisms by which serious Gram positive pathogens cause disease, using the group A streptococcus (Streptococcus pyogenes) as a paradigm.
Principal Investigators
Dr Paras Anand
/test01/channel_2/media/migration/faculty-of-medicine/Dr-Paras-Anand--tojpeg_1461161263759_x4.jpg)
Dr Paras Anand
Non-Clinical Senior Lecturer in Infection
Professor Rosemary Boyton
/test01/channel_2/media/migration/faculty-of-medicine/Rosemary-Boyton--tojpeg_1461161382773_x4.jpg)
Professor Rosemary Boyton
Professor in Immunology and Respiratory Medicine
Professor Christopher Chiu
/test01/channel_2/media/migration/faculty-of-medicine/Chiu,-Christopher--tojpeg_1492684364669_x4.jpg)
Professor Christopher Chiu
Professor of Infectious Diseases
Dr Frances Davies
/test01/channel_2/media/migration/faculty-of-medicine/dr-frances-davies_1635935130967_x4.jpg)
Dr Frances Davies
Honorary Clinical Senior Lecturer
Professor Francis Drobniewski
/test01/channel_2/media/migration/faculty-of-medicine/Drobniewski--tojpeg_1461161492653_x4.jpg)
Professor Francis Drobniewski
Chair in Global Health and Tuberculosis
Professor Carlton Evans
/test01/channel_2/media/migration/faculty-of-medicine/Carlton-Evans--tojpeg_1461161603862_x4.jpg)
Professor Carlton Evans
Professor in Global Health
Mark Gilchrist
/test01/channel_2/media/images/people-list/17-316-icnhs-pulse-089_1672756232487_x1.jpg)
Mark Gilchrist
Professor of Practice
Professor Alison Holmes
/test01/channel_2/media/migration/faculty-of-medicine/Alison-Holmes--tojpeg_1461161758567_x4.jpg)
Professor Alison Holmes
Professor of Infectious Diseases
Dr Michael Jones
/test01/channel_2/media/migration/faculty-of-medicine/Michael-Jones--tojpeg_1461162023975_x4.jpg)
Dr Michael Jones
Emeritus Reader in Molecular Medicine
Dr Tom Parks
/test01/channel_2/media/migration/faculty-of-medicine/tom-parks-photo-2021-1-1617775767997-x1_1618235292940_x4.jpg)
Dr Tom Parks
Clinical Senior Lecturer
Dr Jesus Rodriguez-Manzano
/test01/channel_2/media/migration/faculty-of-medicine/42---9032--t_1491910737410_x1--tojpeg_1576168459508_x4.jpg)
Dr Jesus Rodriguez-Manzano
Senior Lecturer in Diagnostics for Infectious Disease
Professor Sunil Shaunak
/test01/channel_2/media/migration/faculty-of-medicine/portrait;jsessionid=yLvjpTGpv7wzp1DvwzrT2nLyRdVy1nQd1gLQCD2lQk2JdRDBWJKZ!-1704939962--tojpeg_1578305196548_x4.jpg)
Professor Sunil Shaunak
Emeritus Professor in Infectious Diseases
Dr Anika Singanayagam
/test01/channel_2/media/images/people-list/portrait.jpeg)
Dr Anika Singanayagam
Senior Clinical Research Fellow
Dr Valerie Soo
/test01/channel_2/media/images/people-list/Valerie-Soo.jpg)
Dr Valerie Soo
Advanced Research Fellow
Professor Shiranee Sriskandan
/test01/channel_2/media/migration/faculty-of-medicine/Shiranee-Sriskandan--tojpeg_1461161941989_x4.jpg)
Professor Shiranee Sriskandan
Professor of Infectious Diseases
Professor Robert Wilkinson
/test01/channel_2/media/migration/faculty-of-medicine/abt_6036627381460402542MjQ4MzEwNA--tojpeg_1562942931899_x4.jpg)
Professor Robert Wilkinson
Professor in Infectious Diseases
/test01/channel_2/media/migration/faculty-of-medicine/Lai,-Rachel--tojpeg_1568901733576_x4.jpg)